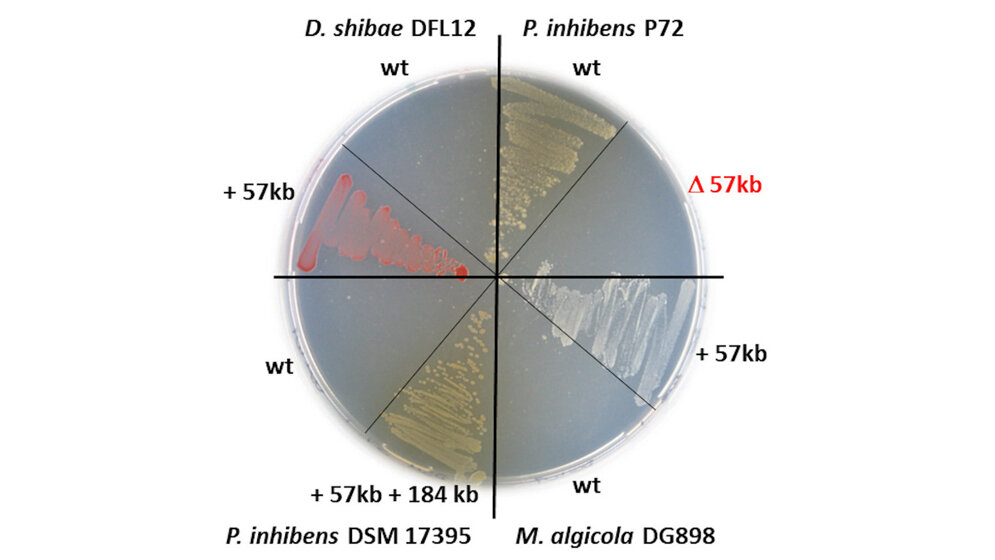
Petrischale_mit_Bakterien_aus_der_Roseobacter_Gruppe_DSMZ.jpg Petrischale mit Bakterien aus der Roseobacter-Gruppe

Einfluss von Aquakulturen auf Antibiotikaresistenzen im Ozean
Roseobacter sind bereits Teil des Resistoms der Weltmeere. Sie machen bis zu einem Viertel der Bakterien in den Ozeanen aus. Die Arbeitsgruppe rund um den Mikrobiologen Privatdozent Dr. Jörn Petersen vom Leibniz-Institut DSMZ-Deutsche Sammlung von Mikroorganismen und Zellkulturen GmbH erforscht im Rahmen des Sonderforschungsbereichs „Roseobacter (TRR51)“ seit einigen Jahren diese Alphaproteobakterien. Sie spielen eine zentrale Rolle im globalen Kohlenstoff- und Schwefelhaushalt und besitzen aufgrund ihres vielseitigen Stoffwechsels ein großes Potential für die biotechnologische Nutzung. Im Rahmen der jetzt veröffentlichten Studie untersuchten die Forscher/-innen eine bisher noch nicht charakterisierte Gruppe von Plasmiden, ringförmigen DNA-Molekülen, die sich unabhängig vom Bakterienchromosom in der Bakterienzelle vervielfältigen. Mit Hilfe von Plasmiden tauschen Bakterien genetisches Material schnell und unkompliziert untereinander aus und tragen damit entscheidend zur Entstehung multiresistenter Krankenhauskeime bei.
Übertragung in weitere Meeresbakterien
Das hier untersuchte RepC_soli Plasmid pP72_e, das die genetische Information für eine um den Faktor 50 erhöhte Toleranz gegenüber dem Breitbandantibiotikum Chloramphenicol enthält, konnte sehr einfach durch eine Art molekulare Rohrpost in weitere Meeresbakterien übertragen werden. Basierend auf ihren Ergebnissen gehen die Forscher/-innen davon aus, dass die in der Studie untersuchten Roseobacter-Stämme aus spanischen Aquakulturen vor relativ kurzer Zeit die Antibiotikaresistenz über horizontalen Gentransfer von entwicklungsgeschichtlich entfernt verwandten Gammaproteobakterien übernommen haben. Untermauert wird die Hypothese von der Tatsache, dass das Resistenzgen bisher in keiner weiteren Art der untersuchten Meeresbakterien gefunden wurde, es aber häufig auf Plasmiden von für Mensch und Tier gefährlichen Krankheitserregern wie Salmonella enterica oder Vibrio cholerae vorkommt.
Genetische Altlast früheren Antibiotikaeinsatzes?
„Da die von uns untersuchten Bakterien von Muscheln aus spanischen Aquakultur-Farmen isoliert wurden, ist davon auszugehen, dass die erworbene Toleranz gegenüber Chloramphenicol eine genetische Altlast früheren Antibiotikaeinsatzes ist“, erläutert der Erstautor der Studie Lukas Birmes. In Aquakulturen seien früher häufig Antibiotika eingesetzt worden, um prophylaktisch möglichen Krankheiten vorzubeugen oder das Wachstum zu fördern. Aufgrund der Konsequenzen für Mensch und Natur sei der Einsatz solcher Medikamente in den letzten Jahren aber in vielen Ländern stark reduziert worden. Bemerkenswert sei, dass in mehr als einem Dutzend anderer nah verwandter Phaeobacter-Stämme, deren Genom komplett entschlüsselt ist und die in den Meeren vor Dänemark, Frankreich, Deutschland und Australien isoliert wurden, das Gen für die Chloramphenicol-Toleranz nicht vorhanden ist. Man wolle keine Schuldzuweisungen aussprechen, stellen die Forscher/-innen klar. „Aber Ergebnisse wie das unsrige zur Verbindung von Gesundheitswesen, Tierzucht und mariner Aquakultur machen deutlich, wie eng die Welt heutzutage aus biologischer Sicht vernetzt ist. Der Mensch sollte sich bewusst sein, welchen Fußabdruck er im Anthropozän hinterlässt“, fasst Jörn Petersen zusammen.
Birmes L, Freese HM, Petersen J (2021): RepC_soli: A novel promiscuous plasmid type of Rhodobacteraceae mediates horizontal transfer of antibiotic resistances in the ocean. Environ Microbiol. 2021 Jan 3, DOI: 10.1111/1462-2920.15380. Online ahead of print.
Quelle: idw/DSMZ
Artikel teilen